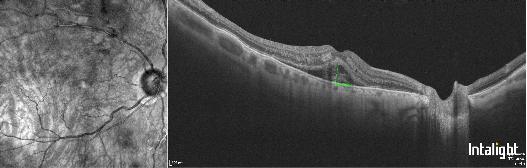
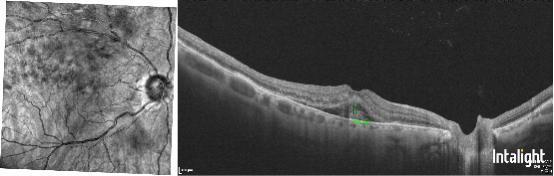

“它不痛不痒、也不红不肿的,怎么突然就看不清了呢?”已经70岁的沈叔(化姓)既焦虑又困惑,他急忙来到广州市第十二人民医院眼科就诊。右眼的突然“失灵”,给他的生活和心理都带来了沉重的打击。
看不清的同时,视物也会变形,出现黑影。该医院眼科主任徐宁主任医师在对沈叔的细致问诊中敏锐发现了这个情况,考虑到沈叔同时还有高血压、血糖偏高的病史,徐宁意识到问题可能位于眼底,立即给沈叔进行了更详细的检查。
检查结果把沈叔吓了一跳,原来是视网膜分支静脉阻塞,俗称眼睛“中风”了!
徐宁介绍,视网膜静脉阻塞是视网膜静脉血管因血栓形成或血流受阻而引发的疾病。就像水管堵塞会导致水流不畅,静脉阻塞后,血液回流受阻,引发视网膜出血、水肿,严重时可能导致视力骤降甚至失明。

徐宁提醒,高血压、高血糖、高血脂是导致视网膜静脉阻塞“三巨头”,还与血液黏稠度和血流动力学异常、熬夜与用眼过度有关,炎症(如结核、梅毒)、口服避孕药、吸烟、酗酒等不良习惯、外伤、青光眼等眼部疾病也是其高危因素。
“当眼睛无端看到黑影或红烟如同墨汁般扩散遮挡了视野、视力突然下降以及视物变形,看直线变弯曲的情况,要警惕是视网膜静脉阻塞病变前期发出的警告。”徐宁提醒,此时应尽快到医院完善眼科检查治疗,做好基础疾病的控制和管理,做到早发现、早治疗,避免视力严重损伤。
文 | 记者 林清清 通讯员 廖温勃
图 | 医院提供